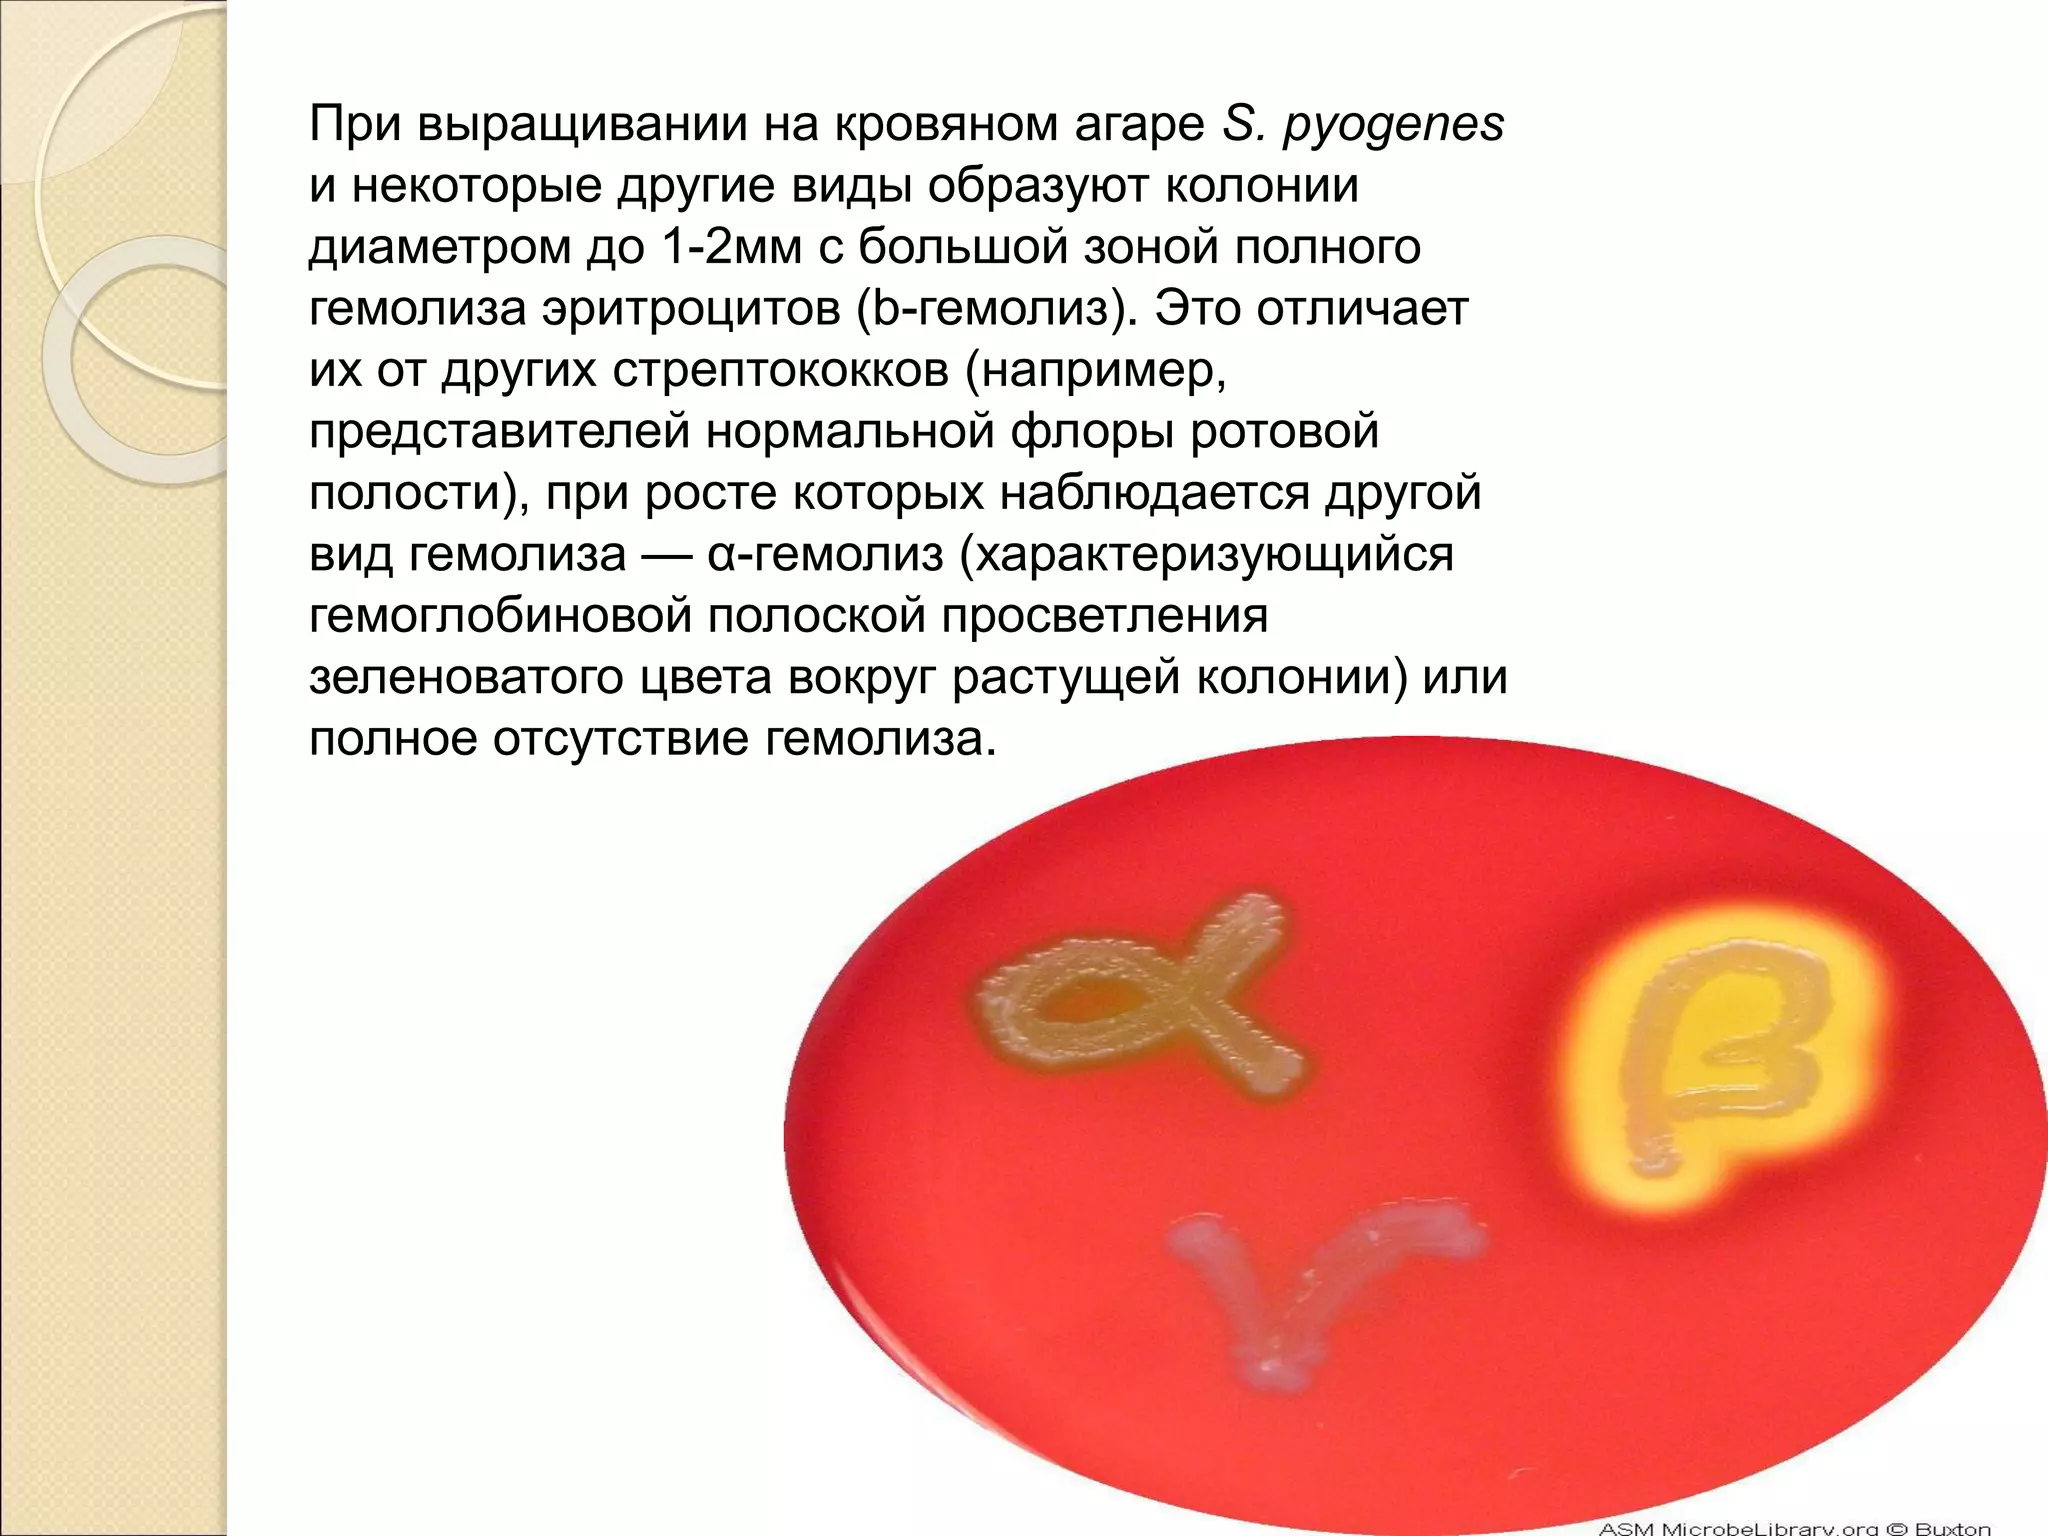
При выращивании на кровяном агаре S. pyogenes
и некоторые другие виды образуют колонии
диаметром до 1-2мм с большой зоной полного
гемолиза эритроцитов (b-гемолиз). Это отличает
их от других стрептококков (например,
представителей нормальной флоры ротовой
полости), при росте которых наблюдается другой
вид гемолиза — α-гемолиз (характеризующийся
гемоглобиновой полоской просветления
зеленоватого цвета вокруг растущей колонии) или
полное отсутствие гемолиза.

Документ рассматривает стрептококковые инфекции, вызываемые бактерией Streptococcus pyogenes, и включает их характеристики, клинические проявления, статистику заболеваемости и потенциальные осложнения. Описаны основные формы инфекции, такие как ангина, скарлатина, рожа и некротизирующий фасциит, а также акцентируется внимание на необходимости своевременной диагностики и лечения для предотвращения серьезных последствий. Проблема стрептококковых инфекций остается актуальной для здравоохранения во всем мире.